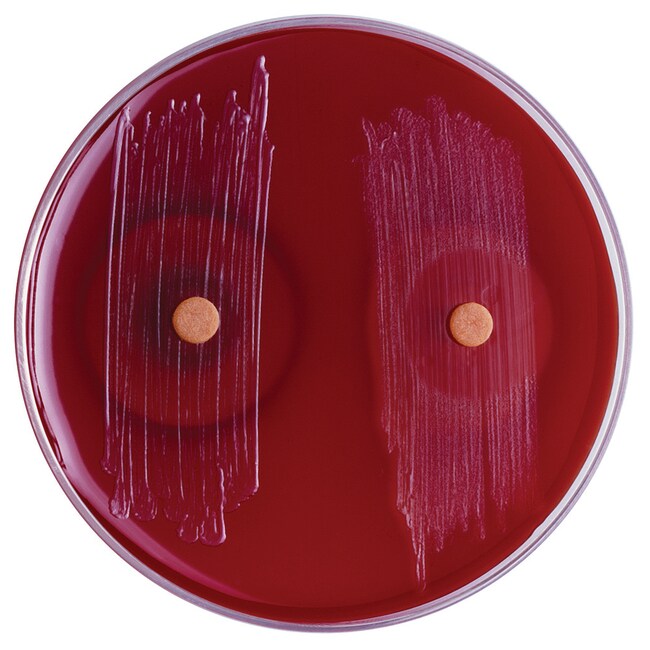

Search
Search
使用本款即用型试剂浸渍纸片,仅需仅需简单的筛选试验,便可区分脆弱拟杆菌群与其他拟杆菌菌种,并可鉴定其他厌氧菌。
| 货号 | 数量 |
|---|---|
| R21122 | 25 片/瓶 |
使用 Thermo Scientific™ Remel™ 胆盐纸片,可区分脆弱拟杆菌群与其他拟杆菌菌种,并可鉴定其他厌氧菌。
Yamazaki 等人替换了先前用于区分脆弱拟杆菌群与其他拟杆菌菌种的胆盐试管1。他们使用了 25 mg 胆盐浸渍的滤纸片。1983 年,Weinberg 等人报告了其使用 15 mg 胆盐纸片得到的类似结果,该纸片有助于明确区分耐胆盐厌氧菌和对胆盐敏感的厌氧菌2。
脆弱拟杆菌是一种厌氧型革兰氏阴性杆菌,常见于人感染中。耐胆盐微生物可以在存在胆盐的情况下生长,并且纸片周围呈耐药生长模式,而对胆盐敏感的微生物则会在胆盐纸片周围呈现出抑制区域。该现象可用于区分脆弱拟杆菌属与其他拟杆菌属细菌,并有助于鉴定其他厌氧菌。脆弱拟杆菌属是一种不会被胆盐抑制的常见厌氧型革兰氏阴性杆菌3。
胆盐纸片含有反应性成分牛胆汁 (15.0 mg/mL)。
并非所有产品在所有国家(地区)均有售。详情请具体咨询。
Remel™ 和 Oxoid™ 产品现已归属 Thermo Scientific 品牌旗下。